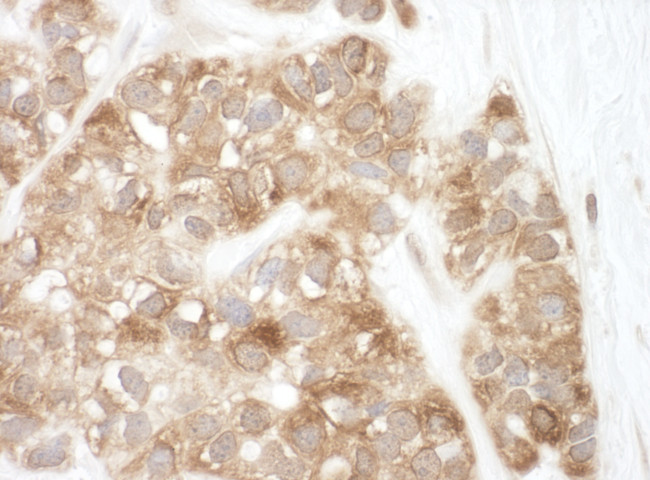
AIF Antibody in Immunohistochemistry (Paraffin) (IHC (P))

Search
Bethyl Laboratories
AIF Polyclonal Antibody
{{$productOrderCtrl.translations['antibody.pdp.commerceCard.promotion.promotions']}}
{{$productOrderCtrl.translations['antibody.pdp.commerceCard.promotion.viewpromo']}}
{{$productOrderCtrl.translations['antibody.pdp.commerceCard.promotion.promocode']}}: {{promo.promoCode}} {{promo.promoTitle}} {{promo.promoDescription}}. {{$productOrderCtrl.translations['antibody.pdp.commerceCard.promotion.learnmore']}}
产品信息
A302-782A
种属反应
宿主/亚型
分类
类型
抗原
偶联物
形式
浓度
规格
纯化类型
保存液
内含物
保存条件
运输条件
产品详细信息
The recommended shelf life for this product is 1 year from date of receipt.
Application Note: For IHC, epitope retrieval with citrate buffer pH 6.0 is recommended for FFPE tissue sections.
靶标信息
Apoptosis Inducing Factor (AIF) causes chromatin condensation and DNA fragmentation. AIF was recently identified, and cloned. Apoptosis is characterized by several morphological nuclear changes including chromatin condensation and nuclear fragmentation. These changes are triggered by the activation of members of caspase family, caspase activated DNase, and several novel proteins. Like the critical molecules, cytochrome c and caspase-9, in apoptosis, AIF localizes in mitochondria. AIF translocates to the nucleus when apoptosis is induced and induces mitochondria to release the apoptogenic proteins cytochrome c and caspase-9. AIF induces chromatin condensation and large scale DNA fragmentation, which are the hallmarks of apoptosis, of the isolated nucleus and the nucleus in live cells by microinjection and apoptosis stimuli. AIF is highly conserved between human and mouse and widely expressed. Mutations in the AIF gene cause combined oxidative phosphorylation deficiency 6, which results in a severe mitochondrial encephalomyopathy. Alternative splicing results in multiple transcript variants of AIF and a related pseudogene has been identified on chromosome 10.
仅用于科研。不用于诊断过程。未经明确授权不得转售。
篇参考文献 (0)
生物信息学
蛋白别名: AG1; AGR1; apoptogenic protein; Apoptosis-inducing factor 1, mitochondrial; apoptosis-inducing factor, mitochondrion-associated, 1; auditory neuropathy, X-linked recessive 1; cell death factor; ER protein 18; ER protein 19; ERP18; ERP19; hAG-1; hTLP19; MGC111425; NADH oxidase; pcd8; PDCD8; PDIA16; programmed cell death 8 (apoptosis-inducing factor); Programmed cell death protein 8; RP3-438D16.2; striatal apoptosis-inducing factor; testicular secretory protein Li 4; TLP19; unnamed protein product; UNQ713/PRO1376
基因别名: AIF; AIFM1; AUNX1; CMT2D; CMTX4; COWCK; COXPD6; DFNX5; NADMR; NAMSD; PDCD8; SEMDHL
UniProt ID: (Human) O95831
Entrez Gene ID: (Human) 9131